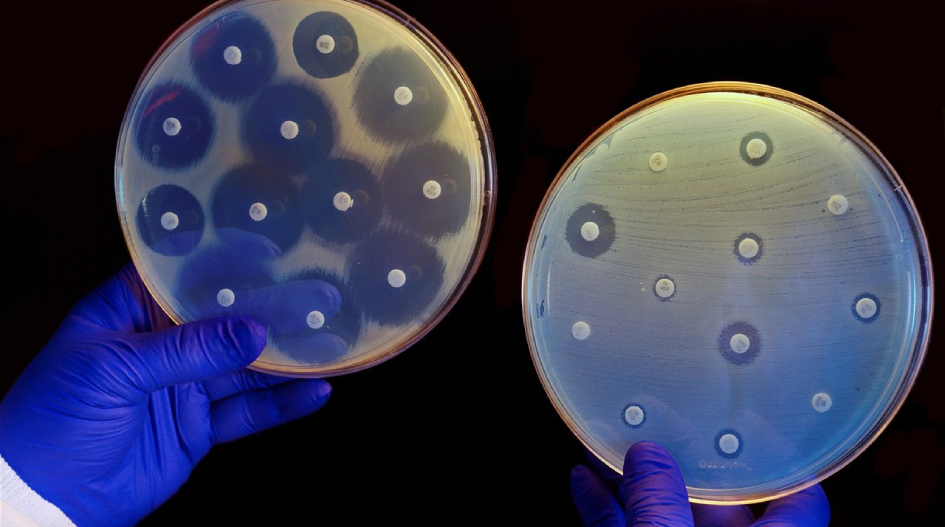

Destacan investigación de docente perteneciente al programa ICEC UCSC
La profesora del Colegio María Inmaculada, Carolina Briones, indagó sobre la “Resistencia bacteriana a los antibióticos”.
Como parte del Programa de Indagación Científica ICEC-UCSC, la profesora del Colegio María Inmaculada de Concepción, Carolina Briones, participó en el X Simposio Internacional de Didáctica de las Ciencias y las Matemáticas junto a la junto a la profesora Yesenia Álvarez. La cita se desarrolló en la ciudad de Barranquilla, Colombia, a finales del año 2022, donde Briones presentó la indagación que realizó sobre “Resistencia bacteriana a los antibióticos”.
“Simulé lo mismo que Fleming hizo cuando descubrió con la penicilina. Lo desarrollé de manera didáctica junto a estudiantes de Tercero y Cuarto Medio del Electivo de Biología Molecular, por lo que la forma de aprender les fue más atractivo”, manifestó la docente. El tema fue destacado en las memorias del evento, en formato revista virtual de la Universidad del Norte, Colombia, en donde se publican los resúmenes de los trabajos presentados.
Sobre la relevancia de este hito, el Coordinador de ICEC UCSC, Dr. Luigi Cuéllar explicó que consideró “la participación de una profesora del sistema escolar chileno, en participar en un evento internacional, algo inédito y más en el marco del desarrollo del Programa Indagación Científica para la Educación en Ciencias, del Mineduc, y desarrollado por la UCSC en las regiones de Biobío y Ñuble. Es fruto de un trabajo colaborativo y persistente, desde al año 2015 con educadoras y profesores de la zona”.
Comunidades de Aprendizaje
Actualmente, la docente del establecimiento penquista se encuentra participando en las Comunidades de Aprendizaje del Programa, donde impulsan indagaciones sobre ecología junto al Colegio Gran Bretaña y el Liceo Técnico Femenino, de la mano de los docentes Luis Fuica y Karen Salas, respectivamente.
En esta oportunidad se encuentran trabajando con estudiantes de Primero Medio, quienes asisten al Parque Alessandri de Coronel a trabajar con ecosistemas. Asimismo, proyectan dirigirse a la zona afectada por los incendios forestales en Santa Juana para hacer trabajo de conteo y ver el impacto ambiente de las especies.
Carolina agradeció esta oportunidad a sus colegas, al Ministerio de Educación y al programa ICEC, del cual forma parte desde 2022 por permitirle fortalecer sus competencias en la investigación y, al mimo tiempo, permitirle generar relaciones con otros recintos educacionales.
“Ella sigue destacando por sus trabajos en su establecimiento, al igual que otros colegas que participan en dichas comunidades. Algunos de ellos han podido también participar de eventos nacionales, financiados por el ICEC Mineduc. Estas instancias se convierten en un paso más en el fortalecimiento del apoyo al profesorado, buscando el mejoramiento de la enseñanza de las ciencias en nuestras escuelas y liceos. Además de ello, el fortalecimiento del liderazgo y la autonomía docente, para poder generar proyectos escolares relacionados con el mejoramiento de la calidad de la enseñanza de las ciencias”, finalizó el Doctor Cuéllar.

